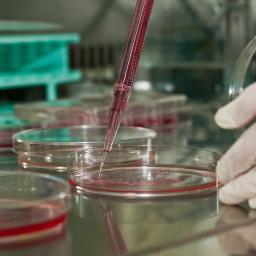
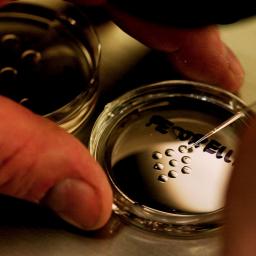

|
by Toby Helm and Henry Zeffman on (#RGDN)
Only the top 10% of farmers would be able to survive due to severe drops in EU subsidiesA British exit from the European Union would have a devastating effect on the nation’s farmers, leaving only the most efficient 10% able to survive without the multi-billion pound subsidies currently handed out by Brussels, says a new report.The study, titled Preparing for Brexit by the independent London-based analysts Agra Europe – who track EU and UK policy, also warns that leaving the EU could damage UK food exports, cause large multinational food companies to relocate away from the UK, and choke off the supply of much-needed seasonal labour from eastern Europe. Continue reading...
|
| Link | http://feeds.theguardian.com/ |
| Feed | http://feeds.theguardian.com/theguardian/science/rss |
| Updated | 2026-06-29 02:45 |
 |
by Alan Yuhas in New York on (#RFQA)
Three young squid caught by marine biologists are the spitting image of their gigantic parents – if nearly 1,000lbs and 50ft smallerMarine biologists have captured three young giant squid, Japanese researchers reported, in what would be the first confirmed catch of very young juveniles of the elusive creature.The young squid, caught off south-western Japan, are replicas of their gigantic parents who live in the deep. Two were caught together; all three weighed less than 1lb and spanned 5-13ins. Adults can reach 50ft and 1,000lbs. Continue reading...
|
 |
by Scott Kelly/EPA on (#RFNS)
Photographs from the Eyewitness series Continue reading...
|
 |
by Letters on (#RF6G)
Today, for World Polio Day, we are joining together to give One Last Push in the battle to end polio for ever.The worldwide campaign against this terrible disease is now reaching a crucial moment. Last year, the World Health Organisation declared India to be polio-free. In July 2015 it announced that Nigeria is also on course for a polio-free future with no new cases detected for 12 months. Only Pakistan and Afghanistan have reported cases of wild poliovirus this year – and total cases are in steep decline. Continue reading...
|
 |
by Alan Yuhas in New York on (#RE69)
TB145, a medium-sized chunk of rock and ice could that cause ‘continental-scale devastation’, will fly by at a distance slightly farther away than the moonA large asteroid discovered only weeks ago will tear past the Earth on Halloween, Nasa has announced, estimating that it will come closer than any object of its size in the next 20 years.The asteroid, nicknamed “the Great Pumpkin†and “Spooky†but technically known as TB145, is an estimated 1,300ft (400 meters) wide – 20 times bigger than the meteorite that screamed across the Russian sky and exploded over Chelyabinsk in 2013, shattering windows with shock waves and debris that injured more than a thousand people. Continue reading...
|
 |
by Ian Sample in Cologne on (#RDZ1)
In an exclusive interview, first British ESA astronaut Tim Peake reveals that despite the dangers of space, his biggest fear is something happening to prevent launch dayHanging on the wall above model rockets and space capsules in the atrium of the European Astronaut Centre in Cologne is a screen showing a timetable of the day’s events. The hall is busy with payload training. Chinese class is underway. After lunch is a lecture on astronaut protective socks. The last event, at 5.30pm, is “Tim’s farewellâ€.The send-off is for Tim Peake, a 43-year-old army major and former helicopter test pilot, who in 2009 was chosen to be Britain’s first European Space Agency (ESA) astronaut. After this week, the staff here will not see him again until May 2016. By then, Peake will have blasted into space, lapped the planet more than 2,700 times, and fallen through the atmosphere in a fireball.
|
 |
by Averil Macdonald on (#RDT9)
I was criticised for my comments saying women react differently to men because of their understanding of science. Here’s what we should doI have spent my career communicating to people about the importance and excitement of science in their daily lives and hopefully inspiring younger people, particularly girls, to study and build careers in science and technology. It is vital for our country’s continued economic health that we maintain and grow the science base, and women have had and will have increasingly a bigger role to play in that.Related: Women 'less likely than men to support fracking, due to instinct' Continue reading...
|
 |
by Susanna Rustin on (#RD1E)
Academic posts at Oxford and Cambridge, a stint as head of an NHS trust, and now chair of the science museum: whatever Jeffrey’s travails, Dame Mary Archer knows she’s been lucky. Here she talks about women in science, museum cuts – and the husband-shaped elephant in the roomDame Mary Archer has brought a book along to our interview. The Meaning of Success: Insights from Women at Cambridge was published last year by the university where she used to teach. “Its thesis, that success for a woman is perhaps more broadly based than for a man, is absolutely true,†she says briskly. In other words, when it comes to life-work balance, she thinks women are more bothered than men about life.It is early on Monday morning, and we are drinking tea at the Science Museum in London. In January, Archer became chair of its board of trustees, an appointment made by the prime minister. This is the first interview she has given to a national newspaper since then. She is a formidable presence, immaculately presented in a green suit and jewellery to match her striking eyes on the day we meet, and so encased in her new persona of culture-sector grandee that I can’t help but feel impertinent as I weigh up the questions I plan to ask about her starring role in one of the most famous political scandals of the last century. Continue reading...
|
by Stuart Clark on (#RCZP)
The largest astronomical image ever made has been released by astronomers, together with an online tool to help you explore it.Lose yourself in the glorious star fields of the Milky Way. Astronomers at the Ruhr-Universität Bochum (RUB) have compiled the largest astronomical image ever made and released it to the general public.The full image is a mosaic of 268 individual images. It is contained in a single data file of 194 Gigabytes. Made up of 46 billion pixels, it is so huge that the astronomers have provided an online tool to help view it. Continue reading...
 |
by Olivia Maynard on (#RCMV)
E-cigarettes are used by millions in the UK, but information about them is sometimes conflicting. So what is the current evidence on them?It has been described as a ‘disruptive technology’ potentially capable of breaking our fatal relationship with tobacco. So the setting for a public debate on e-cigarettes - a museum part-funded by the tobacco industry, in a city home to the global headquarters of one of the largest tobacco manufacturers - was perhaps ironic. Yet on Wednesday evening, I found myself at the M-Shed in Bristol, watching just that: a debate about whether e-cigarettes could be part of the solution to the tobacco epidemic.To mark the launch of a new Integrative Cancer Epidemiology Programme, linked to the Medical Research Centre Integrative Epidemiology Unit at the University of Bristol, Professor Marcus Munafò (Professor of Biological Psychology at the University of Bristol) and Professor Linda Bauld (Professor of Health Policy at the University of Stirling), both collaborators of mine, discussed e-cigarettes. Professor Gabriel Scally (Public Health Doctor and former Regional Director of Public Health for the South West of England) chaired the discussion. Continue reading...
|
 |
by Jo Blason on (#RCAW)
A newborn seal pup, a new species of tortoise and wild yaks are among this week’s pick of images from the natural world Continue reading...
|
 |
by Andy Brunning on (#RC9Q)
Sometimes you just want a caffeine hit to wake you up, but if you appreciate the finer points of a cup of coffee, it’s worth going right down to the chemistry of the water, milk, sugar – and salt
|
by Oliver Balch on (#RC6H)
Harnessing data for healthcare provision and research is improving, but barriers such as privacy concerns, mistrust and medical culture are holding it backWhen Anil Sethi’s sister was diagnosed with stage four breast cancer, it reinforced to him the lack of control patients in the US have over their own health data. In a fragmented system, where a patient may see many clinicians across different states who are all bound by strict data disclosure regulations, it can be a rigmarole to have to explain each time their current and past medications, the results of recent lab tests, past diagnoses and so forth.Sethi’s response is Gliimpse. The veteran healthcare entrepreneur is developing an app which aims to digitise health by downloading “health information that is available to [patients] on distributed and fragmented portalsâ€. It will give people an online mechanism for collating essential medical data and converting it into a more understandable format.
Coalition committee tries to balance climate science briefings by inviting denialists from thinktank
by Graham Readfearn on (#RBDJ)
Climate scientists have been briefing Australian politicians this week. But one session did not go to planAustralian MPs and senators have been attending briefings in Canberra this week by some of our country’s world-leading climate scientists.
 |
by Stuart Clark on (#RATP)
Nasa’s veteran Cassini spacecraft is on course for a daring encounter with Saturn’s moon Enceladus on 28 October. It will pass the icy moon at an altitude of just under 30 miles.Enceladus is the sixth largest moon of Saturn, orbiting the planet at a distance of 147,886 miles from its centre. It has intrigued scientists since 2005 when Cassini recorded plumes of water jetting from its south pole. The close pass next week is designed to make Cassini plunge through these vapour curtains. Continue reading...
|
 |
by Guardian Staff on (#RAB9)
Disease has been present for twice as long as previously thought, and was originally spread by human-to-human contact, not fleas, says new studyPlague has been a human scourge for more than twice as long as had previously been thought, new research suggests. Continue reading...
|
by Daniel Freeman and Jason Freeman on (#R9BP)
The benefits of reducing alcohol consumption hit the headlines this week, but how can we begin to address the deeply-rooted issue of problem drinking?“What is most unhealthy is this identification we have … where we identify having a good time with drinking alcohol, having a shit time with drinking alcohol, being happy with drinking alcohol, being sad with drinking alcohol. It is too much of an ever-present, regardless of our mood.â€Nicola Sturgeon, speaking to Alastair Campbell in this month’s GQ, has a point. Sturgeon was referring to Scotland but her comments could easily be applied to the rest of the UK. Indeed with almost a quarter of men and 18% of women in England exceeding the recommended weekly limits for alcohol consumption, it seems the time has come for an urgent discussion about the implications of our infatuation with booze. Continue reading...
 |
by Guardian Staff on (#R8K0)
A Nasa animation demonstrates how a star would be ripped apart if it got too close to a black hole in space. When a star enters close proximity to a black hole, intense tidal forces rip the star apart. Stellar debris is flung outward at high speed while the rest of the star descends towards the black hole, causing a flare Continue reading...
|
 |
by Suzanne Goldenberg, US environment correspondent on (#R84H)
Full-page newspaper advertisement by ex-military and foreign policy leaders is aimed at Republicans who want to block action on cutting carbon emissionsNearly 50 leaders of America’s defence and foreign policy establishment are calling on political and business leaders to “think past tomorrow†and lead the fight on climate change.
|
by Oliver Milman on (#R81V)
Turnbull earned a standing ovation at a celebratory dinner in Canberra on Wednesday when he handed out the prime minister’s prizes for scienceAt an awards ceremony for the nation’s leading scientists, Malcolm Turnbull has promised to build an Australia that “invests in science and puts it right at the centre of our national agendaâ€.
 |
by James Meikle on (#R7M7)
Potentially ‘game-changing’ trial will take up to 12 years and monitor 11,000 patientsThe world’s largest clinical trial to investigate whether taking aspirin every day stops the recurrence of some of the most common cancers is to be funded by Cancer Research UK and the NHS.About 11,000 patients from more than 100 centres across the UK will be recruited for the study. It will take up to 12 years and involve two groups taking different daily doses of aspirin, either 100mg or 300mg, and one taking dummy, or placebo, tablets. Continue reading...
|
 |
by Oliver Milman on (#R7GD)
Researchers in Australia and Germany find crocodiles deploy ‘unilateral eye closure’ while dozing in order to keep a close eye on potential threats or preyIf you ever thought you could safely tiptoe past a sleeping crocodile, please reconsider – scientists have confirmed that the fearsome reptiles sleep with one eye open.Researchers in Australia and Germany have discovered that crocodiles can deploy “unilateral eye closure†while dozing to keep a close eye on potential threats or prey. Continue reading...
|
 |
by Mahita Gajanan in New York on (#R78V)
Several recent studies report that whether you’re the first-born, middle or oldest child has little to do with personality development or intelligenceBlaming your problems on being a middle child might no longer work.Theories about the link between birth order and personality have been hotly debated for years, but several recent studies report that birth order has little to with personality development. Continue reading...
|
by Paul Simons on (#R78X)
Oak leaves in Britain are still mostly green. The oak is one of the last trees to change colour in autumn, although many have already dropped their acorns. But the days of finding lots of big acorns may be drawing to a close since they are falling victim to climate change.A study of acorns has revealed that the warmer the weather the smaller the crop of acorns. Tim Sparks, a professor at Coventry University, has examined more than 160,000 observations of oaks and found that the more the first dates of flowering vary in springtime the poorer the acorn crop. In warmer springs the oak trees flower in a less synchronised fashion over a longer period and this gives a smaller crop of acorns in autumn, a drop of about 20%. Continue reading...
 |
by Denis Campbell Health policy editor on (#R75X)
US survey shows older people who follow vegetable-rich diet have brain volume greater than those who do notEating a Mediterranean diet rich in fish and vegetables may help prevent your brain shrinking for as long as five years, new research suggests.People who follow such a diet, which also involves consuming less meat and dairy products than average, end up with bigger brains and slow down the ageing process, according to the US study. Continue reading...
|
 |
by Associated Press in Washington on (#R756)
|
 |
by Henry Nicholls on (#R6T5)
A genetic study of giant tortoises on the Galapagos island of Santa Cruz reveals two different species and causes some head scratching amongst taxonomistsIn 1902, American naturalist Rollo Beck stepped ashore on the Galapagos island of Santa Cruz. He’d been urged by his patron Walter Rothschild “to leave no stone unturned†in his efforts to collect giant tortoises from the island and “after a long and wearisome hunt,†he came up trumps. One of the seven specimens Beck collected became the type specimen for the tortoises on this island, now referred to as Chelonoidis porteri.But just over a century later, in 2005, geneticists demonstrated that there appear to be two distinct species on the island. The two lineages live just 20 km apart yet the clear genetic differences indicate they have been heading in different evolutionary directions for at least 1.7 million years. Continue reading...
|
by Ian Sample Science editor on (#R6JK)
Earth’s final days are in the distant future, but the the death of a far-off solar system revealed in images from Kepler 2 shows how the world might endThe destruction of a solar system has been captured for the first time by astronomers who said the violent events provide a grim glimpse of Earth’s ultimate fate.Images taken by Nasa’s Kepler 2 space mission reveal the rocky remains of a world that is being torn apart as it spirals around a dead star, or white dwarf, in the constellation of Virgo, 570 light years from Earth.
 |
by Natalie Day on (#R62G)
A new book, which charts the remarkable transformation of Arizona State University, offers lessons for university leaders in the UK.
|
 |
by Press Association on (#R5WY)
Parasitic wasp spotted at Kent nature reserve is confirmed to be new genus and species to BritainA species of wasp that has never been recorded in the country has been discovered at a British nature reserve.The parasitic wasp, Lymantrichneumon disparis, now known to be a genus and a new species to Britain, was found by a butterfly collector at the RSPB’s Broadwater Warren near Royal Tunbridge Wells, Kent. Continue reading...
|
by Dean Burnett on (#R5HS)
Yet another upset caused by “mental patient†Halloween costumes suggests that many people still consider this a valid option. If they will insist on dressing like people with mental health problems, they may as well do it accurately.Another year, another Halloween approaching, another business gets called out for thinking mental illness is a perfectly fine idea for a Halloween costume.While it’s not the first time this has happened, things may be improving; the portrayal of mental illness in the media is not as bad as it once was, and the establishment responsible for this latest incident at least responded quickly and effectively. Continue reading...
 |
by Nigel Fountain on (#R5G4)
Father of the space shuttle who played a vital role in the Apollo 11 moon landingOn 21 May 1961, soon after the Soviet Union had launched Yuri Gagarin into space and in the aftermath of the abortive Bay of Pigs invasion of Cuba, the beleaguered US president, John F Kennedy, made a rash promise to Congress. He pledged that the US would land an American on the moon and get the astronaut safely back “before this decade is outâ€. The systems engineer George Mueller, who has died aged 97, was a key reason why Kennedy’s pledge was fulfilled on 20 July 1969, as Neil Armstrong and Buzz Aldrin stepped on to the moon.Mueller arrived at Nasa as associate administrator for manned space flight in September 1963, just weeks before Kennedy’s assassination. He immediately commissioned an assessment of the prospects of fulfilling Kennedy’s goal. The odds were one in 10, he was told. Between 1963 and 1966, Mueller, drawing on his experience of US air force methods, transformed Nasa. Continue reading...
|
 |
by Michael Halpern on (#R5BT)
After nine years of government attacks on Canadian research, the science community is looking forward to a fresh start under Justin Trudeau.There was a palpable outpouring of relief from Canadian scientists as the Liberal Party won a majority on Monday night, bringing to an end nine years of escalating hostility by the Harper government towards its own research base. Drastic cuts to funding and constraints on scientific freedom have significantly damaged Canadian research and its capacity to develop science-based public health and environmental policies.Harper’s assault on science was extensive: with government scientists censored, budgets chopped, data monitoring programs eliminated, scientific libraries shuttered and the contents thrown into dumpsters. The long form census was axed, depriving decision makers of vital information about their citizens. Continue reading...
|
 |
by Reuters on (#R564)
UV filtering chemical is killing off baby coral around tourist resorts, particularly in the Caribbean and HawaiiA common ingredient found in sunscreen is toxic to coral and contributing to the decline of reefs around the world, according to new research.Oxybenzone, a UV-filtering chemical compound found in 3,500 brands of sunscreen worldwide, can be fatal to baby coral and damaging to adults in high concentrations, according to the study published on Tuesday in the Archives of Environmental Contamination and Toxicology. Continue reading...
|
 |
by James Wilsdon on (#R4YQ)
The Wellcome Trust today unveils its new strategy, with a commitment to spend more and spend smarter in areas where it can make the biggest difference.A month out from the November spending review, Britain’s scientists are braced for bad news. Rumours continue to swirl about another five years of flat budgets, a likely merger of research councils, and the culling of other funding bodies. Next Monday, the pressure group Science is Vital is hosting a rally at Conway Hall in London where prominent voices from across the research community will spell out the case for public investment.So in these uncertain times, today’s announcement by the Wellcome Trust is a shot in the arm for UK science. The trust, which is now the second highest-spending foundation in the world, will significantly boost the amount it invests in research, to a total of £5 billion over the next five years. The ambition of this is clear when set against £6 billion that the trust has spent over the past decade, and £11 billion since it was first set up in 1936. Continue reading...
|
 |
by Richard Lea on (#R51Q)
First editions of Darwin, Newton, Humboldt and Kepler among groundbreaking works going on saleNinety works spanning three centuries of scientific inquiry are to go under the hammer at Christie’s in December, in an attempt to plug a £2m hole in the finances of the UK’s most venerable science charity, the Royal Institution.The groundbreaking works in the history of medicine, science and the natural world include first editions from scientific luminaries such as Charles Darwin, Isaac Newton, Leonhard Euler, Johannes Kepler and Alexander von Humboldt. They will be put up for auction on 1 December 2015. The selection ranges from the 16th to the 19th century, many of the volumes given added lustre by their connection to an institution founded in 1799 for “diffusing the knowledge†of science and technology. Continue reading...
|
 |
by Oliver Milman on (#R4MV)
Energy stored from roof panels could offer the cheapest electricity alternative within three years, Climate Council study says
|
 |
by Maria Gruzdeva and Anastasiia Fedorova for The Cal on (#R4WJ)
Documenting the country’s space centres, photographer Maria Gruzdeva offers a rare look inside the secretive facilities, still in use today. The Calvert Journal reports Continue reading...
|
|
by Australian Associated Press on (#R4AD)
Oriental liver fluke responsible for the deaths of 26,000 people a year secretes a growth factor that accelerates wound healing and blood vessel growthResearchers have found a cancer-causing parasitic worm responsible for the deaths of about 26,000 people a year could prove useful in healing chronic wounds such as diabetic ulcers.Research by a team at James Cook University in Queensland has found the 1cm-long oriental liver fluke secretes a growth factor that accelerates wound healing and blood vessel growth in tests on mice and cell cultures. Continue reading...
|
 |
by Associated Press in Cairo on (#R48S)
Restorers give progress report as they attempt to rectify damage done when beard was broken by worker, then bodged back together with everyday glueRestorers have put their work on the famed golden burial mask of King Tutankhamun on display in Cairo, over a year after the beard was accidentally knocked off and hastily glued back on with epoxy.A German-Egyptian team of experts showed off the mask in a laboratory in the Egyptian Museum, detailing plans for how the epoxy will be scraped off and the beard carefully removed before being reattached by a method to be determined by a joint scientific committee. Continue reading...
|
 |
by Julia Kollewe on (#R3VB)
British government, Alzheimer’s Research UK and big six pharmaceutical companies backing what they claim is first initiative of its kindGlaxoSmithKline and five other major drugmakers have teamed up with the UK government to launch the world’s first venture capital fund dedicated to finding new ways to prevent and treat dementia.The Department of Health, the charity Alzheimer’s Research UK and the six pharmaceutical firms have raised $100m (£65m) to invest in early-stage, novel treatments for Alzheimer’s, Parkinson’s disease and other forms of dementia. GSK’s boss, Sir Andrew Witty, has been one of the main driving forces behind the initiative, in which the company is joined by the US drugmakers Johnson & Johnson, Biogen, Eli Lilly and Pfizer, and Japan’s Takeda. Continue reading...
|
 |
by Guardian Staff on (#R33C)
Speaking the day after attending “Astronomy Night†at the White House, Ahmed Mohamed, aka ‘clock boy’, says he is wants to get a positive message out. The 14-year-old says “It’s not about the colour of your skin or about your religion, but it’s about your heart.†President Obama briefly met Mohamed as he shook hands with students at the event, giving the student a hug Continue reading...
|
 |
by Associated Press in Chicago on (#R2GD)
Updated guidelines recommend annual breast cancer screenings at age 45 instead of 40 and less often, switching to every other year at age 55New mammogram advice from the American Cancer Society says most women should start annual screenings at age 45 instead of 40, a change that moves the group closer to guidelines from an influential advisory taskforce.The cancer group also now advises switching to screening every other year at 55. The taskforce recommends starting routine screening for breast cancer at age 50, then every other year. Continue reading...
|
 |
by Guardian Staff on (#R28V)
President Obama is joined by Nasa astronauts and young scientists at the White House. Among the guests was a Texas teenager who brought homemade clock to school which was mistaken for a bomb. Obama said Nasa was working toward a mission to send humans to Mars in the 2030s. Photograph: Chip Somodevilla/Getty Images Continue reading...
|
 |
by Anthony Smith on (#R274)
My father, Raymond Smith, who has died aged 90, was a major figure in postwar social anthropology. His work, and his life, were focused on kinship in the Caribbean and the US. His gift and his good fortune was to be a friend and supporter of the first generation of West Indian scholars to reach maturity as independence became a reality. Together they put social sciences on the map at the University of the West Indies in the 1960s.Undertaking field work in British Guiana (now Guyana), he met Flora Tong, a social worker and teacher seconded to work with him as a research assistant, and began his long engagement with the politics and sociology of the Caribbean. One of his earliest books, British Guiana (1962), combined an account of the country’s social history with an analysis of its racial politics, which are depressingly familiar 60 years later. Continue reading...
|
 |
by Rory Carroll in Los Angeles on (#R0RG)
Texas schoolboy arrested over homemade clock chats to US president – aka geek-in-chief – at White House astronomy night, urges against judging people on looksAhmed Mohamed, the Texas teenager arrested after teachers mistook his homemade clock for a bomb, met Barack Obama at the White House on Monday night.
|
|
by Ian Sample Science editor on (#R082)
Data from several clinics in the US suggests that test boosts pregnancy rates by 10 percentage points, although it has not yet been approved for use in the UKA test that checks for abnormal amounts of DNA in IVF embryos has raised pregnancy rates at US fertility clinics that have started to offer the procedure.Scientists in Oxford who helped develop the test claim it can boost the chances of an IVF pregnancy by 10 percentage points, leading to success rates of about 75% in 35-year-old women. Continue reading...
|
 |
by GrrlScientist on (#QZVD)
Prey species evolve a variety of ways to avoid predators, including camouflage, conspicuous colouration, and chemical toxins. But a new study of amphibians indicates that evolving toxins against predators increases the rate of extinction for prey speciesPrey species evolve a variety of ways to avoid their predators, including chemical toxins, camouflage, and conspicuous colouration. But what are the potential costs associated with anti-predator defences? According to a study of amphibians published today in the journal, Proceedings of the National Academy of Sciences, chemical defence and conspicuous colouration enhance speciation rates in prey species, as predicted. But unexpectedly, evolution of chemical defences also increases extinction rates -- even above the rate of speciation. As a result, developing chemical defences against predators increases the overall risk of extinction for prey species. Continue reading...
|
 |
by Press Association on (#QZMV)
Discovery, if confirmed, indicates that living organisms appeared on Earth 4.1 billion years ago, remarkably soon after its formationLiving organisms may have existed on Earth as long as 4.1bn years ago – 300m years earlier than was previously thought, new research has shown.If confirmed, the discovery means life emerged a remarkably short time after the Earth was formed from a primordial disc of dust and gas surrounding the sun 4.6bn years ago. Continue reading...
|
 |
by Mo Costandi on (#QZ36)
German doctors report an unusual case of reflex epilepsy
|